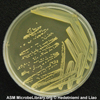

STAPHYLOCOCCUS AUREUS -UZROČNIK
ALIMENTARNE INTOKSIKACIJE
 MORFOLOŠKE KARAKTERISTIKE I OSOBINE UZROČNIKA
MORFOLOŠKE KARAKTERISTIKE I OSOBINE UZROČNIKA
Staphylococcus aureus (zlatni stafilokok) je bakterija loptastog oblika koja se po Gramu boji pozitivno. Nepokretna je i ne stvara sporu. Neki sojevi imaju kapsulu. Fakultativno je anaerobni mikroorganizam. Na mikroskopskom preparatu imaju izgled grozdastih nakupina po čemu je Stafilokok i dobio ime. Prvi put ih je opisao škotski hirurg Alexander Ogston, 1882.god. Svrstan je u Genus Staphylococcus koji ima više vrsta i podvrsta.
Među nesporogenim bakterijama stafilokoki su najotporniji na nepovoljne uslove okoline, pa se mesecima može održavati u smrznutoj ili sasušenoj hrani. Dobro podnosi visoke koncentracije soli i šećera.
Osetljiv je na sve dezinficijense koji se danas koriste, a temperatura iznad 60˚ C ga uništava
Stafilokok se dobro razmnožava na sobnoj temperaturi, lučeći svoj egzotoksin u aerobnim i anaerobnim uslovima.
PATOGENOST
Staphylococcus aureus produkuje više vrsta toksina koji izazivaju različite biloške efekte na ćelije čoveka i drugih sisara. Najpoznatiji toksini koji učestvuje u mehanizmu nastanka gastroenteritisa uzrokovanog Staphylococcus aureus-om su enterotoksini.
Do danas ih je identifikovano i opisano 20 seroloških tipova ovih toksina (A, B, C, C1, C2, C3, D, E, F, H, G, I...). Nastaju vrlo brzo tokom umnožavanja bakterija u kontaminiranoj hrani. Količina izlučenih enterotoksina zavisi od uslova rasta bakterijske ćelije ( temperatura, pH, prisustvo ili odsustvo kiseonika). Zbog svoje strukture otporni su na toplotu i na crevne enzime (proteaze). Mogu preživeti i više od 30 minuta na temperaturi od 100°C tako da termičkom obradom namirnica žive stafilokoke budu eliminisane, ali toksini ostaju neoštećeni. Najčešće uključeni u trovanja hranom su toksin A i D, pojedinačno ili u kombinaciji. Za enterotoksin A vezano je oko 75% slučajeva trovanja prouzrokovanih stafilokokama. U zadnje vreme kao mogući proizvodači enterotoksina označeni su pored zlatnog stafilokoka i Staph. intermedius i Staph. hycus. Jedan enterotoksičan soj Stafilokoka može da produkuje više različitih tipova enterotoksina
REZERVOAR INFEKCIJE I PUTEVI PRENOŠENJA
Prirodni rezervoar je čovek i neke domaće životinje. Nalazi se na koži i sluzokoži zdravih osoba kao prolazna flora. Stafilokok se može naći u guši i nosu u oko 50 % zdrave populacije. Prisutni su i na predmetima opšte upotrebe, ali i u mleku, siru, mesu i drugim prehrambenim proizvodima, gde najčešće dospevaju nepažnjom i niskom ličnom higijenom obolelih lica. Ove namirnice su pogodne za nastavak razmnožavanja sa istovremenim lučenjem termostabilnog egzotoksina. Tako se često dešavaju masovna trovanja burekom, zbog upotrebe kontaminiranog sira ili mesa. Česta su i masovna, eksplozivna trovanja sladoledom, bilo da je sladoled pravljen od kontaminiranog mleka ili jaja u prahu, ili da je naknadno kontaminiran prilikom proizvodnje, transporta ili prodaje. Sve vrste mlevenog mesa predstavljaju vrlo pogodnu sredinu za razmnožavanje bakterija. Šunke mogu biti proizvod visokog rizika po zdravlje ljudi kada su u pitanju stafilokokna trovanja, ukoliko u naknadnoj manipulaciji dođe do njihove kontaminacije jer sadržaj soli i rezidualnog nitrita ne predstavlja prepreku za razmnožavanje stafilokoka. Nisu sigurna ni kuvana jela, ako su kontaminirana i ostavljena 3-5 h na sobnoj temperaturi, zbog izlučenog egzotoksina koji ostaje patogen za čoveka i posle uticaja visoke temperature.. Stafilokokno trovanje najčešće se javlja u letnjim mesecima.
KLINIČKA SLIKA
Alimentarnu intoksikaciju izazivaju samo oni sojevi žutog stafilokoka, koji luče enterotoksin. Alimentarna intoksikacija je akutni gastroenteritis, izazvan stafilokoknim egzotoksinom koji je prethodno izlučen u hrani. Patogeni efekat enterotoksina se nemože uništiti kad se prokuvaju ili ispeku namirnice u kojima je već izlučen jer je ovaj toksin termostabilan. Broj mikroorganizama dovoljan da proizvede količinu toksina koja izaziva oboljenje je (> 106/g).
Inkubacija je veoma kratka, svega 2-6 h. Bolest počinje naglo iz punog zdravlja. Prvo se javlja vrtoglavica, zatim malaksalost, mučnina i nelagodnost u stomaku. Veoma brzo počinje nezadrživo povraćanje sadržaja hrane, zatim želudačnog soka i na kraju žuči. Bolest je praćena vrlo jakim grčevima u stomaku i učestalim stolicam. Bolesnik ima u toku jednog dana 10-30 stolica, koje su vodenaste i vrlo obilne.Bolest nije praćena povećanjem telesne temperature. Posle samo nekoliko časova bolesnik je malaksao, intoksiciran, adinamičan, lice mu je bledo, pokriveno hladnim znojem, oči su upale i bolesnik se oseća krajnje iscrpljeno. Osim toga, javljaju se veoma bolni grčevi u listovima. Stanje kardiovaskularnog kolapsa je manje ili više izraženo: hipotenzija, tahikardija, hladni i plavičasti ekstremiteti. Stomak je difuzno osetljiv, sa čujnom i veoma živom peristaltikom.
Zbog veoma burnog početka sa sklonošću ka hipotenziji i šoku, često je potrebna urgentna intervencija.
Stafilokokno trovanje traje 1-2 dana pa povraćanje i proliv spontano prestaju posle 24-48h. Za to vreme bolesnik može da izgubi 3-8 kg. Bolest se završava brzim i potpunim izlečenjem.
Alimentarna intoksikacija može da liči na trovanje hranom izazvano salmonelama, na akutna hirurška oboljenja u stomaku, trovanje pečurkama i teškim metalima, infarkt …
Mogući su i smrtni ishodi, naročito dece i starih osoba.
DIJAGNOZA
se postavlja na osnovu kliničke slike i epidemioloških podataka pogotovo u slučaju masovnog trovanja Etiološka dijagnoza je moguća na osnovu direktnog izolovanja i dokazivanja mikrorganizma iz ostataka konzumirane hrane.
se postavlja na osnovu kliničke slike i epidemioloških podataka pogotovo u slučaju masovnog trovanja Etiološka dijagnoza je moguća na osnovu direktnog izolovanja i dokazivanja mikrorganizma iz ostataka konzumirane hrane.
LEČENJE
Lečenje je simptomatsko i uključuje nadoknadu izgubljene tečnosti i elektrolita i borbu protiv bola u stomaku. Lakšim bolesnicima se prvenstveno daju topli napitci ( čajevi, tople supe, pirinčana voda) a težim izotonični fiziološki rastvor i rastvor glukoze u infuziji). Dijeta je sastavni deo lečenja. Bolesnik uzima samo tečnosti dok traje proliv. Kad glavne tegobe prestanu, u ishranu se uvode pečene jabuke, dvopek, pire od krompira, sutlijaš. Kada se stolica počne normalizovati, u ishranu se uvode i proteini: nemasno meso, kuvano ili pripremljeno na žaru, mlad sir itd. Bolesnik prelazi na normalnu ishranu posle 10 dana. Antibiotska terapija uglavnom nije potrebna. Široka i nekritična upotreba antibiotika brzo dovodi do stvaranja rezistentnih sojeva. Meticilin rezistentni stafilok je jedan od najpoznatijih primera.
PREVENCIJA
 Najbolji način prevencije jeste sprečavanje mogućnosti kontaminacije hrane tokom proizvodnje i obrade. Kontinuirana kontrole u procesu proizvodnje na tzv. kritičnim kontrolnim tačakama na kojima najverovatnije može doći do kontaminacije obezbeđuje više mogućnosti za utvrđivanje kontaminacije pre nego što se hrana isporuči na tržište.
Najbolji način prevencije jeste sprečavanje mogućnosti kontaminacije hrane tokom proizvodnje i obrade. Kontinuirana kontrole u procesu proizvodnje na tzv. kritičnim kontrolnim tačakama na kojima najverovatnije može doći do kontaminacije obezbeđuje više mogućnosti za utvrđivanje kontaminacije pre nego što se hrana isporuči na tržište.
Otkrivanje kliconoša, redovnim sanitarnim nadzorom zaposlenih u proizvodnji i distribuciji hrane, kao i redovna mikrobiološka kontrola namirnica u prometu, naročito onih napravljenih od mleka i mesa.
Pravilno čuvanje i skladištenje svežih namirnica, kao i ostataka pripremljene hrane na temperaturi frižidera smanjuje mogućnost naknadne kontaminacije, kao i umnožavanje bakterija. Sprovođenje higijenskih mera redovnim pranjem ruku u procesu pripreme i distribucije namirnica. Prije pripreme hrane, temeljno oprati ruke vodom i sapunom, kao i pribor kojim se služite pri pripremi jela. Da bi se sprečila unakrsna kontaminacija izbegavati kontakt sveže i nepripremljene sa termički obrađenom hranom, preko pribora i posuđa koje se koristi u pripremi. Ne koristiti namirnice koje su promenile boju, miris ili su počele da trule.
Autor: Mavrak dr Snježana, spec. mikrobiologije sa parazitologijom
Ponedeljak - petak 07-15 časova

Prijem uzoraka: ponedeljak-petak 7-9:30h
PCR testiranje na lični zahtev: ponedeljak-petak 10-12h
